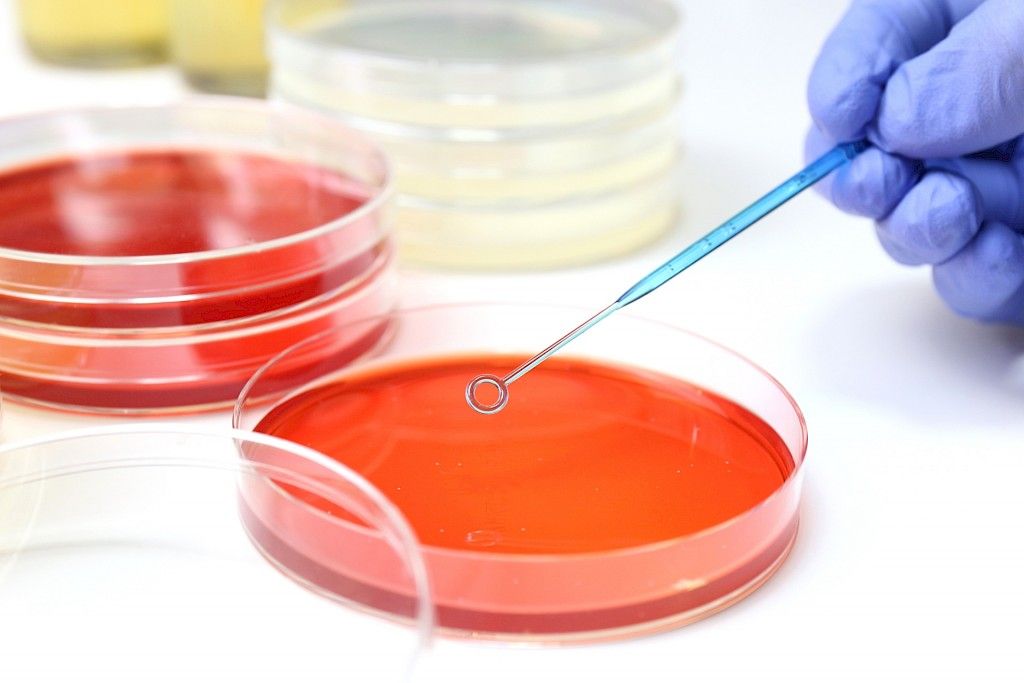

Vuodeosastopotilaista 8,8 prosentilla oli vähintään yksi hoitoon liittyvä infektio, osoitti tutkimus suomalaisissa akuuttisairaaloissa.
Käytännössä kaikki maan akuuttisairaalat osallistuivat Euroopan tautikeskuksen prevalenssitutkimukseen, jossa selvitettiin hoitoon liittyviä infektioita ja mikrobilääkkeiden käyttöä. Osa sairaaloista rajasi psykiatrian osastoja pois tutkimuksesta.
Tutkittuja potilaita oli 9 079, ja heistä 803:lla oli tutkimuspäivänä hoitoon liittyvän infektion oireita tai hoito meneillään.
Tällaisten infektioiden esiintyvyys oli suurin tehohoitoyksiköissä ja hematologisilla potilailla. Yleisimmät infektiotyypit olivat leikkausalueen infektio, vakava yleisinfektio ja keuhkokuume.
Tavallisimpia aiheuttajamikrobeja olivat Staphylococcus aureus ja Escherichia coli. Niiden osuus oli selvästi suurempi kuin edellisessä vastaavassa tutkimuksessa v. 2011.
Resistentit mikrobit olivat edelleen harvinaisia. MRSA- ja CPE-kantoja löytyi kumpaakin vain yksi. ESBL-E. coli -kantojen aiheuttamia infektioita todettiin yhtä monta kuin edellisessä tutkimuksessa.
Mikrobilääkkeitä käytettiin vähemmän kuin vuonna 2011.
– Huolestuttavaa sen sijaan oli laajakirjoisten mikrobilääkkeiden, erityisesti meropeneemin, osuuden kasvu. Kirurgisessa profylaksissa suuntaus oli oikea: yhden annoksen kuurien osuus oli suurentunut, kirjoittajat toteavat.
Lähde: Sarvikivi E, Toura S, Arifulla D, Lyytikäinen O. Hoitoon liittyvien infektioiden esiintyvyys Suomessa 2016. Suom Lääkäril 2018;73:2641–6.
Kirjoittaja:
Suvi Sariola
toimittaja
Kuva: Fotolia
Artikkeli julkaistaan Lääkärilehdessä 45/2018.